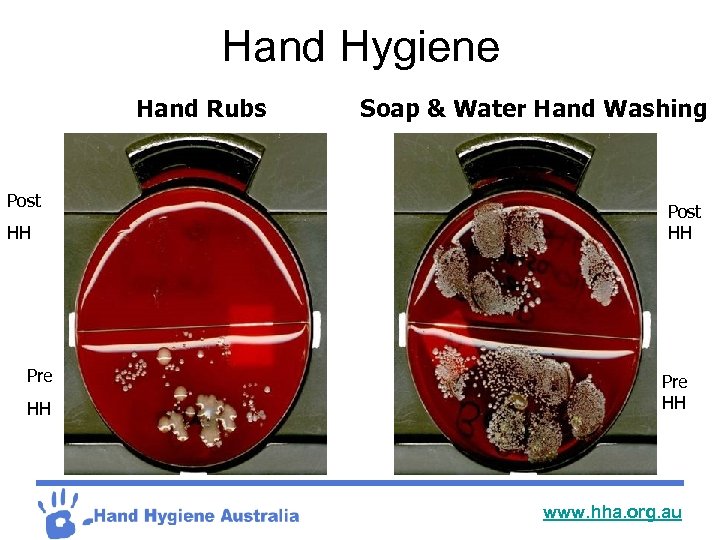
Hand Hygiene Hand Rubs Post HH Pre HH Soap & Water Hand Washing Post

7f80afa6dd88a5028b9735f7483ff9a0.ppt
- Количество слайдов: 32
 Hand Hygiene for Clinical staff www. hha. org. au
Hand Hygiene for Clinical staff www. hha. org. au
 What is it? ? ? ? ? Hand Hygiene is : A process to reduce the number of microorganisms on hands by • using soap and water to wash and dry hands thoroughly or • using waterless hand rubs( eg. Alcohol based hand rub) www. hha. org. au
What is it? ? ? ? ? Hand Hygiene is : A process to reduce the number of microorganisms on hands by • using soap and water to wash and dry hands thoroughly or • using waterless hand rubs( eg. Alcohol based hand rub) www. hha. org. au
 History of Hand Hygiene I Doctors in Mesopotamia (circa 1750 BC) lost their hands I Disciples of Jesus lost their seat I Semmelweiss lost his mind I Onlookers encouraged to “have a feel” I “House of Crime” I Ruining medical practice…. . I Flo “cleanliness over Godliness” www. hha. org. au
History of Hand Hygiene I Doctors in Mesopotamia (circa 1750 BC) lost their hands I Disciples of Jesus lost their seat I Semmelweiss lost his mind I Onlookers encouraged to “have a feel” I “House of Crime” I Ruining medical practice…. . I Flo “cleanliness over Godliness” www. hha. org. au
 Hand Hygiene I Hand hygiene is generally poorly adhered to across the board from all levels of Health Care Workers I Most staff underestimate the time and frequency they spend on hand hygiene I What about you? ? www. hha. org. au
Hand Hygiene I Hand hygiene is generally poorly adhered to across the board from all levels of Health Care Workers I Most staff underestimate the time and frequency they spend on hand hygiene I What about you? ? www. hha. org. au
 Why bother? ? I 7 -10% of patients will acquire 1 or more healthcare acquired infections (HCAI’s) I Contributes to 7, 000 deaths per annum I Fed Gov. spends >$950 M AUD annually on HCAI’s I Av. HCAI cost $3500+ increases LOS 4+days I MRSA BSI approx $22, 000 - high mortality rates 35% I Increased LOS 14+ days. >$108 M AUD/annum I Surgical site infections cost >$268 M AUD/annum I Enormous problem: Approx. 6. 1 infections/100 pts I Majority are preventable Source: Australian Council for Quality and Safety in Healthcare July 2003 Yung, Mc. Donald, Spelman, Street & Johnson 2001 Victorian Surveillance System (VICNISS) Coordinating Centre Data 2007 www. hha. org. au
Why bother? ? I 7 -10% of patients will acquire 1 or more healthcare acquired infections (HCAI’s) I Contributes to 7, 000 deaths per annum I Fed Gov. spends >$950 M AUD annually on HCAI’s I Av. HCAI cost $3500+ increases LOS 4+days I MRSA BSI approx $22, 000 - high mortality rates 35% I Increased LOS 14+ days. >$108 M AUD/annum I Surgical site infections cost >$268 M AUD/annum I Enormous problem: Approx. 6. 1 infections/100 pts I Majority are preventable Source: Australian Council for Quality and Safety in Healthcare July 2003 Yung, Mc. Donald, Spelman, Street & Johnson 2001 Victorian Surveillance System (VICNISS) Coordinating Centre Data 2007 www. hha. org. au
 What we did…. • • • Austin/Geneva template VQC project 6 Vic Pilot sites Over 2 years Pilots HH compliance increased from 21% to 47% • Pilots saved $1. 2 M with 53 less than predicted MRSA BSI (statistically significant) • Statewide Roll out • 76 hospitals over 12 months • Stage 1 HH compliance increased from 18% to 51% • Stage 2 HH compliance increased from 21% to 54% • Reduction in both MRSA isolates and MRSA BSIs • National HH Initiative…… www. hha. org. au
What we did…. • • • Austin/Geneva template VQC project 6 Vic Pilot sites Over 2 years Pilots HH compliance increased from 21% to 47% • Pilots saved $1. 2 M with 53 less than predicted MRSA BSI (statistically significant) • Statewide Roll out • 76 hospitals over 12 months • Stage 1 HH compliance increased from 18% to 51% • Stage 2 HH compliance increased from 21% to 54% • Reduction in both MRSA isolates and MRSA BSIs • National HH Initiative…… www. hha. org. au
 Goals of National Hand Hygiene Initiative…. I Reduce HCAIs I Change attitudes/culture I Collect HH compliance data – 3 audits per year I Collect SAB data I HH products to be available in all public areas I Develop consumer targeted HH campaign to raise awareness and expectations I Sustain HH culture change I Benchmark HH compliance nationally and internationally www. hha. org. au
Goals of National Hand Hygiene Initiative…. I Reduce HCAIs I Change attitudes/culture I Collect HH compliance data – 3 audits per year I Collect SAB data I HH products to be available in all public areas I Develop consumer targeted HH campaign to raise awareness and expectations I Sustain HH culture change I Benchmark HH compliance nationally and internationally www. hha. org. au
 How We Can Achieve These Goals…. • • Strong organisational leadership Leadership at every departmental level HH champions Mandatory annual HH on line learning package for all new and current employees • Make HH core business for all HCWs • Long term-open public reporting • Hand hygiene is ‘everyone’s responsibility’ www. hha. org. au
How We Can Achieve These Goals…. • • Strong organisational leadership Leadership at every departmental level HH champions Mandatory annual HH on line learning package for all new and current employees • Make HH core business for all HCWs • Long term-open public reporting • Hand hygiene is ‘everyone’s responsibility’ www. hha. org. au
 Outcome Indicators Hand hygiene compliance Data collection Data entry Data analysis Staphylococcus aureus Bacteraemia measurement of total MRSA/MSSA isolates & bacteraemia per 100 separations and/or 1000 occupied bed days per month All collected locally by facility, by state and nationally with benchmarking possible with countries participating in the WHO “Clean care is Safer Care” initiative www. hha. org. au
Outcome Indicators Hand hygiene compliance Data collection Data entry Data analysis Staphylococcus aureus Bacteraemia measurement of total MRSA/MSSA isolates & bacteraemia per 100 separations and/or 1000 occupied bed days per month All collected locally by facility, by state and nationally with benchmarking possible with countries participating in the WHO “Clean care is Safer Care” initiative www. hha. org. au
 Desired Outcome………. . INCREASE HH Compliance INCREASE Awareness DECREASE Healthcare acquired infections www. hha. org. au
Desired Outcome………. . INCREASE HH Compliance INCREASE Awareness DECREASE Healthcare acquired infections www. hha. org. au
 Reasons why we don’t clean our hands…. I Takes too long I Skin irritation I Sinks poorly located I Too busy I I only touched “it” a little bit I I forgot I I meant too/I thought I did I I will next time I I didn’t know you were watching www. hha. org. au
Reasons why we don’t clean our hands…. I Takes too long I Skin irritation I Sinks poorly located I Too busy I I only touched “it” a little bit I I forgot I I meant too/I thought I did I I will next time I I didn’t know you were watching www. hha. org. au
 What we did to help…. Introduced: I Isopropyl Alcohol impregnated wipes/detergent wipes I Alcoholic Chlorhexidine hand rubs(ABHR) I Compatible moisturiser www. hha. org. au
What we did to help…. Introduced: I Isopropyl Alcohol impregnated wipes/detergent wipes I Alcoholic Chlorhexidine hand rubs(ABHR) I Compatible moisturiser www. hha. org. au
 Why use ABHR’s? ? IReduces bacterial count on hands IMore effective for standard hand wash IReduces adverse outcomes and cost associated with HAI’s IRequires less time ILess irritating contain an emollient ICan be readily accessible/portable www. hha. org. au
Why use ABHR’s? ? IReduces bacterial count on hands IMore effective for standard hand wash IReduces adverse outcomes and cost associated with HAI’s IRequires less time ILess irritating contain an emollient ICan be readily accessible/portable www. hha. org. au
 When to use ABHRs? ? IWhen hands are NOT visibly soiled IBefore and after touching a patient IAfter glove use IAfter contact with inanimate objects I CDC; Guideline for hand hygiene in health-care settings, 2002 www. hha. org. au
When to use ABHRs? ? IWhen hands are NOT visibly soiled IBefore and after touching a patient IAfter glove use IAfter contact with inanimate objects I CDC; Guideline for hand hygiene in health-care settings, 2002 www. hha. org. au
 What can I use? ? HH means either: Iusing soap and water to wash with thorough drying Iwhen your hands are visibly soiled or Iusing a waterless hand rubs ( eg. ABHR) Iwhen your hands are visibly clean www. hha. org. au
What can I use? ? HH means either: Iusing soap and water to wash with thorough drying Iwhen your hands are visibly soiled or Iusing a waterless hand rubs ( eg. ABHR) Iwhen your hands are visibly clean www. hha. org. au
 www. hha. org. au
www. hha. org. au
Hand Hygiene Hand Rubs Post HH Pre HH Soap & Water Hand Washing Post HH Pre HH www. hha. org. au
Hand Hygiene Hand Rubs Post HH Pre HH Soap & Water Hand Washing Post HH Pre HH www. hha. org. au
 When do I do it at work…. www. hha. org. au
When do I do it at work…. www. hha. org. au
 Gloves…. 1. Gloves should be used as an adjunct to, not a substitute for hand hygiene. 2. Hand hygiene is to be used before & after all glove use. 3. Gloves need to be changed & ABHR used after each pt procedure and when going from dirty to clean sites even on the same patient. 4. Disposable gloves are to be used once only and not disinfected or washed. www. hha. org. au
Gloves…. 1. Gloves should be used as an adjunct to, not a substitute for hand hygiene. 2. Hand hygiene is to be used before & after all glove use. 3. Gloves need to be changed & ABHR used after each pt procedure and when going from dirty to clean sites even on the same patient. 4. Disposable gloves are to be used once only and not disinfected or washed. www. hha. org. au
 “Clean Between” I Use the alcohol impregnated wipes/detergent wipes on all shared non critical equipment I Think about product placement to encourage use e. g near keyboards, on trolleys, in clinic areas, therapy rooms www. hha. org. au
“Clean Between” I Use the alcohol impregnated wipes/detergent wipes on all shared non critical equipment I Think about product placement to encourage use e. g near keyboards, on trolleys, in clinic areas, therapy rooms www. hha. org. au
 Healthcare worker education AIM: To develop & maintain an ongoing education programme to initiate & sustain hand hygiene behaviour change. www. hha. org. au
Healthcare worker education AIM: To develop & maintain an ongoing education programme to initiate & sustain hand hygiene behaviour change. www. hha. org. au
 Role Models…. I We are all role models all the time I All our patients/clients/residents deserve to see us clean our hands I Lead by example Influence of role Models on hand hygiene of healthcare workers “Healthcare workers in a room with senior staff member or peer who DID NOT wash hands were significantly less likely to wash their own hands” it read EMERGING INFECTIOUS DISEASES FEB 2003 www. hha. org. au
Role Models…. I We are all role models all the time I All our patients/clients/residents deserve to see us clean our hands I Lead by example Influence of role Models on hand hygiene of healthcare workers “Healthcare workers in a room with senior staff member or peer who DID NOT wash hands were significantly less likely to wash their own hands” it read EMERGING INFECTIOUS DISEASES FEB 2003 www. hha. org. au
 Who can use it? ? I Health care workers I Patients/Clients/Residents I Visitors I Place HH products in high traffic areas I Educate everyone to use before and after each session/appointment I Lead by example www. hha. org. au
Who can use it? ? I Health care workers I Patients/Clients/Residents I Visitors I Place HH products in high traffic areas I Educate everyone to use before and after each session/appointment I Lead by example www. hha. org. au
 Think about your patients Remember many patients are bed bound and can’t get up to perform HH so offer ABHR or soap and water basin and towel I After a bed pan/urinal I Before their meals I After a physiotherapy session I Before they retire for the night I Before visiting hours I Whenever they ask…. www. hha. org. au
Think about your patients Remember many patients are bed bound and can’t get up to perform HH so offer ABHR or soap and water basin and towel I After a bed pan/urinal I Before their meals I After a physiotherapy session I Before they retire for the night I Before visiting hours I Whenever they ask…. www. hha. org. au
 Compatible Moisturiser…. Used minimum of 3 times per shift IAt coffee break IAt meal breaks IAt home time IAll HCW’s to use hospital supplied compatible moisturiser(boys included) IThink about the whole 24 hours www. hha. org. au
Compatible Moisturiser…. Used minimum of 3 times per shift IAt coffee break IAt meal breaks IAt home time IAll HCW’s to use hospital supplied compatible moisturiser(boys included) IThink about the whole 24 hours www. hha. org. au
 Hand health…. Your skin is your 1 st line of defence against infections I Cover cuts, scratches, rashes with an water proof dressing I Keep wounds clean I Don’t pick sores I Don’t touch open wounds I Wear gloves the garden I Wear gloves for the dishes I Think about the whole 24 hours www. hha. org. au
Hand health…. Your skin is your 1 st line of defence against infections I Cover cuts, scratches, rashes with an water proof dressing I Keep wounds clean I Don’t pick sores I Don’t touch open wounds I Wear gloves the garden I Wear gloves for the dishes I Think about the whole 24 hours www. hha. org. au
 Nails…. Don’t bite your fingernails IKeep nails short INo chipped polish INo acrylic nails in clinical areas ILimit jewellery worn to work IJewellery should not inhibit your ability to correctly perform HH www. hha. org. au
Nails…. Don’t bite your fingernails IKeep nails short INo chipped polish INo acrylic nails in clinical areas ILimit jewellery worn to work IJewellery should not inhibit your ability to correctly perform HH www. hha. org. au
 At work…… I At work we are in close contact with each other I Have clean hands before you start I Wipe down shared equipment e. g keyboards, phones, torches etc I Wipe your lanyard daily I Stay home if ill www. hha. org. au
At work…… I At work we are in close contact with each other I Have clean hands before you start I Wipe down shared equipment e. g keyboards, phones, torches etc I Wipe your lanyard daily I Stay home if ill www. hha. org. au
 Where we are now…. www. hha. org. au
Where we are now…. www. hha. org. au
 Hand Hygiene SUSTAINABILITY ? This is not just an Infection Control problem it belongs to the whole hospital www. hha. org. au
Hand Hygiene SUSTAINABILITY ? This is not just an Infection Control problem it belongs to the whole hospital www. hha. org. au
 Take home message…. I Look after your skin I Remind others to practice healthy hands habits I Use moisturiser (boys included) I Wear gloves I Don’t bite your nails I Make it an effective wash I Stay healthy www. hha. org. au
Take home message…. I Look after your skin I Remind others to practice healthy hands habits I Use moisturiser (boys included) I Wear gloves I Don’t bite your nails I Make it an effective wash I Stay healthy www. hha. org. au
 References: 1. Pittet D, Boyce J. Hand Hygiene and patient care: pursuing the Semmelweiss legacy. The Lancet Infectious Diseases 2001: April: 9 -20 2. Centre for Disease Control and Prevention. “Guideline for Hand Hygiene in health care settings: recommendations of the Healthcare Infection Control practices Advisory Committee and the HICPAC/SHEA/APIA/IDSA Hand Hygiene Task force”, Morbidity and Mortality Weekly Report, 2002: 51(No. RR-16) 3. Victorian Quality Council Hand Hygiene Project. “A practical model for implementing hand hygiene in hospitals”. Austin Health Coordinating centre, First edition 2004. 4. History of infection Control and its Contributions to the Development and Success of Brain Tumour Operations. Miller et al, 2005. Medscape article 5. Larsen EL. APIC Guideline Committee. APIC guideline for handwashing and hand antisepsis in health care settings. Am J Infect control 1995: 23: 251 -69 6. HHA, 5 Moments for Hand Hygiene, Advanced draft, version 4, 2008 www. hha. org. au
References: 1. Pittet D, Boyce J. Hand Hygiene and patient care: pursuing the Semmelweiss legacy. The Lancet Infectious Diseases 2001: April: 9 -20 2. Centre for Disease Control and Prevention. “Guideline for Hand Hygiene in health care settings: recommendations of the Healthcare Infection Control practices Advisory Committee and the HICPAC/SHEA/APIA/IDSA Hand Hygiene Task force”, Morbidity and Mortality Weekly Report, 2002: 51(No. RR-16) 3. Victorian Quality Council Hand Hygiene Project. “A practical model for implementing hand hygiene in hospitals”. Austin Health Coordinating centre, First edition 2004. 4. History of infection Control and its Contributions to the Development and Success of Brain Tumour Operations. Miller et al, 2005. Medscape article 5. Larsen EL. APIC Guideline Committee. APIC guideline for handwashing and hand antisepsis in health care settings. Am J Infect control 1995: 23: 251 -69 6. HHA, 5 Moments for Hand Hygiene, Advanced draft, version 4, 2008 www. hha. org. au


